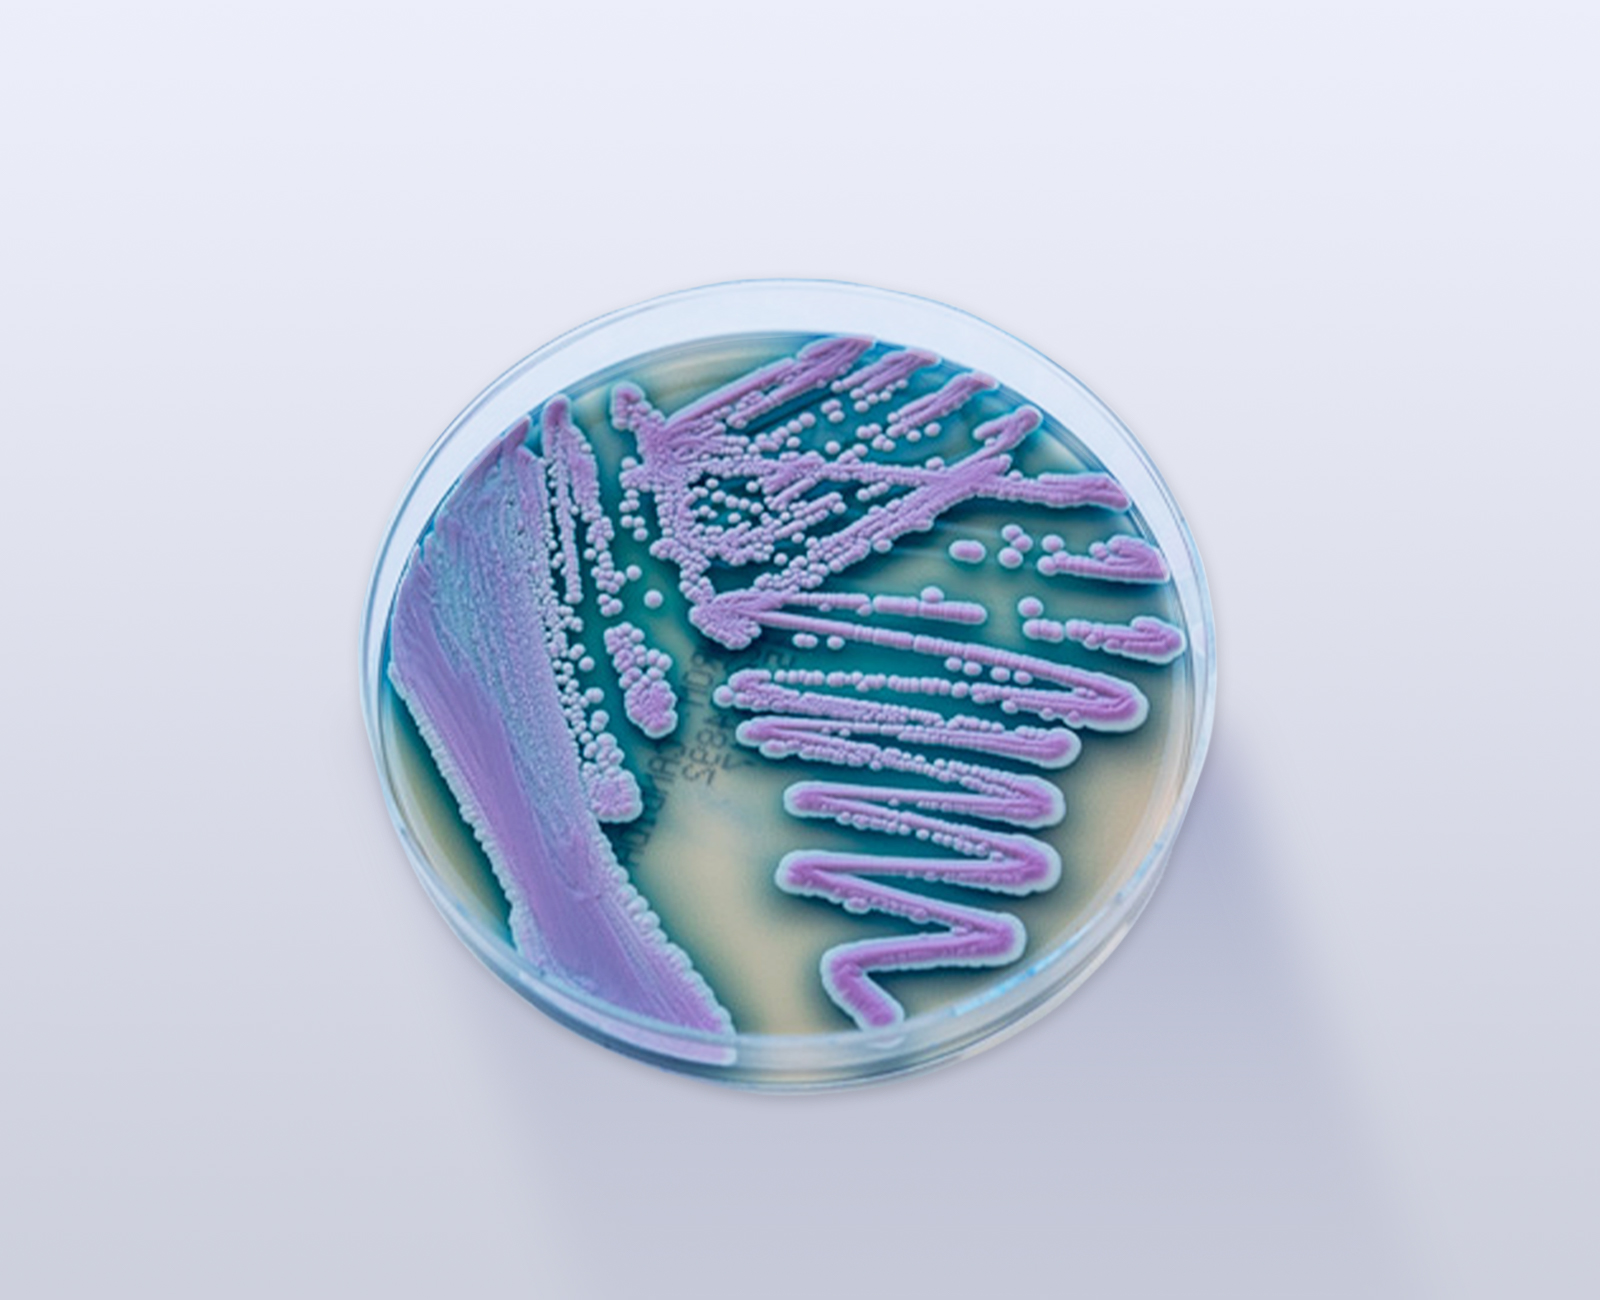
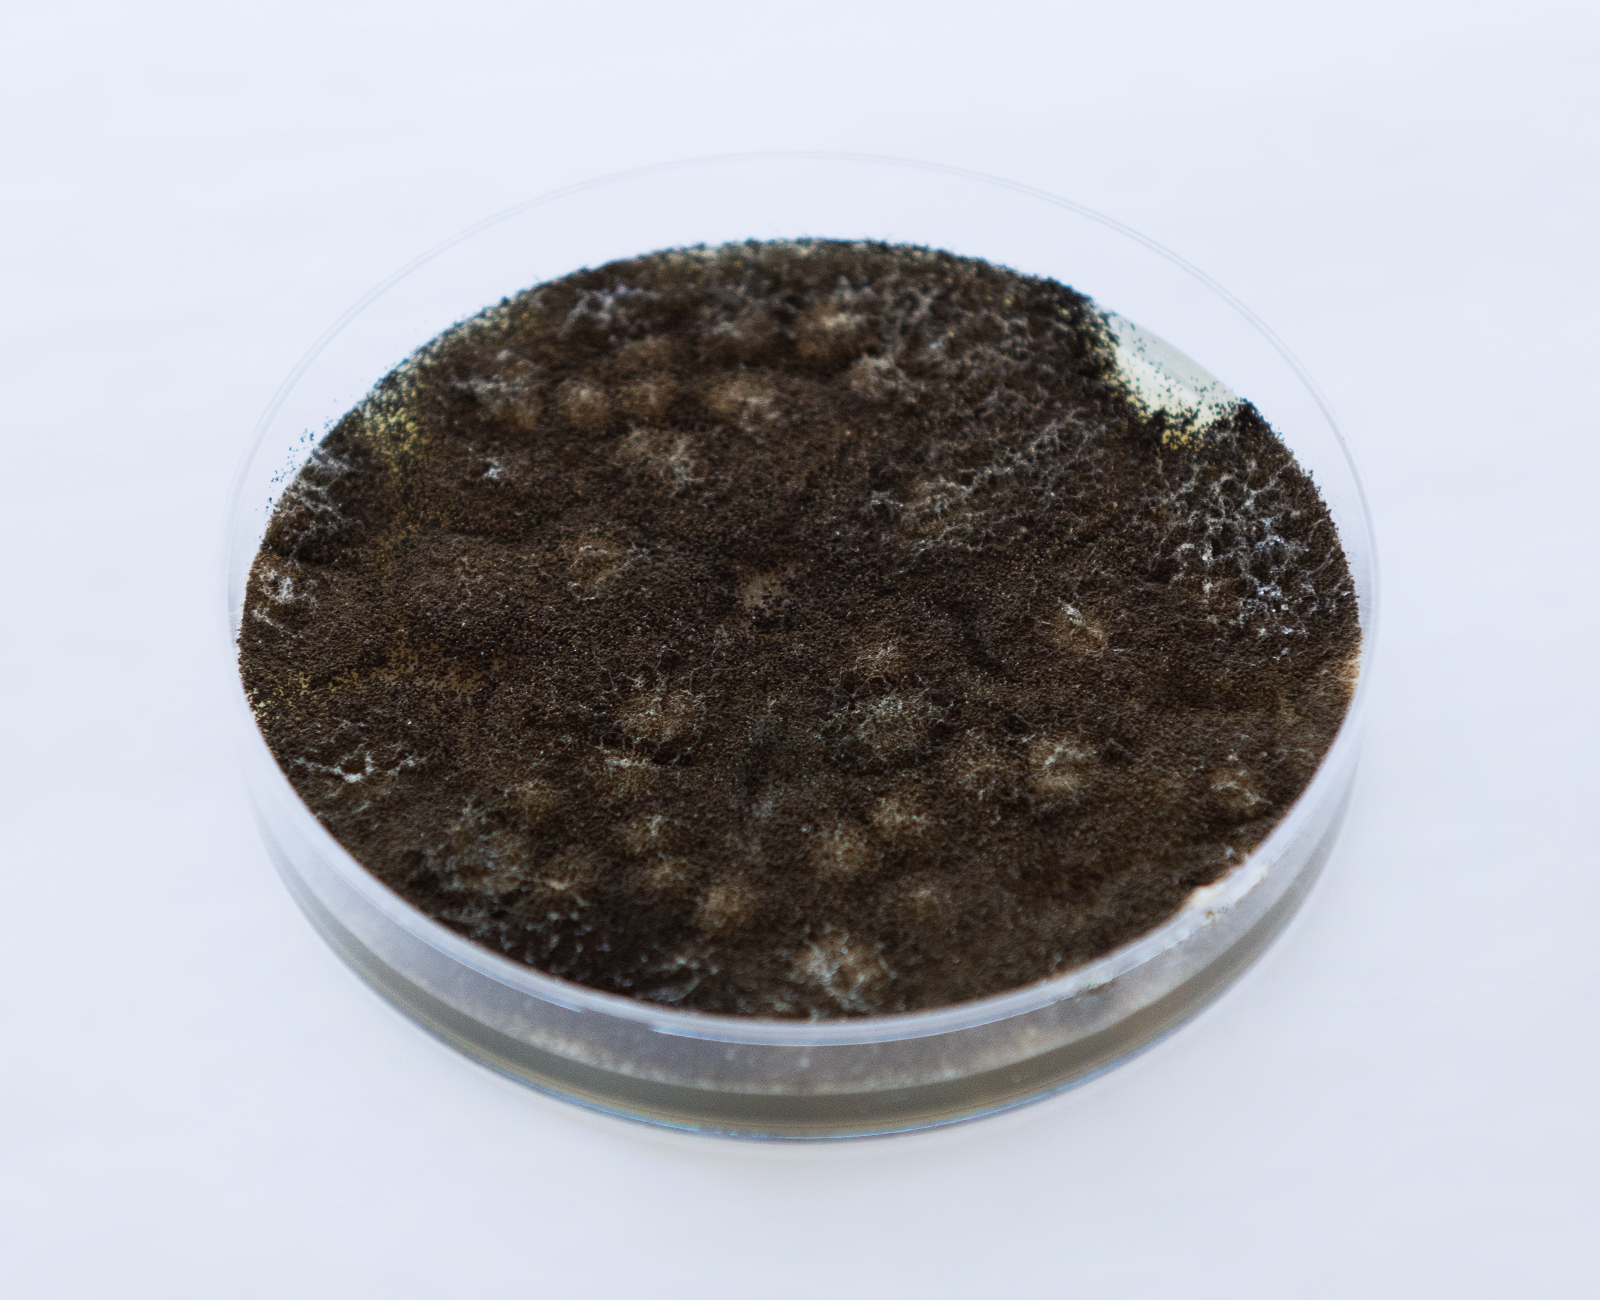

Recentemente, os Estados Unidos registraram o primeiro caso de uma infecção sexualmente transmissível causada pelo fungo Trichophyton mentagrophytes tipo VII. O paciente, um homem de 30 anos, desenvolveu uma erupção cutânea vermelha e com coceira nas pernas, na virilha e nas nádegas após uma viagem à Inglaterra, Grécia e Califórnia. O caso foi publicado na JAMA Dermatology por médicos da NYU Langone Health, em Nova York.
O tratamento do paciente incluiu fluconazol, terbinafina e itraconazol, levando quatro meses e meio para a cura completa. Embora a infecção tenha sido transmitida por contato sexual, há a possibilidade de que o fungo tenha sido adquirido em uma sauna.
As doenças fúngicas estão em expansão global, com uma crescente resistência aos tratamentos e a falta de vacinas licenciadas para preveni-las ou tratá-las. Segundo a revista The Lancet Infectious Diseases, as mortes anuais por doenças fúngicas podem chegar a 3,75 milhões, muito acima das estimativas anteriores.
Dentre essas infecções, a Candida é um problema significativo em cuidados intensivos e outras condições médicas graves. A Candida auris, em particular, é notável por sua resistência a múltiplos medicamentos e sua capacidade de causar surtos em ambientes hospitalares. Para enfrentar esses desafios, é essencial contar com métodos eficazes de diagnóstico e isolamento desses fungos.
A Plastlabor está atenta a essas descobertas e oferece soluções avançadas para o diagnóstico e isolamento de fungos patogênicos. Entre elas, destacamos:
- CHROMagar™ CANDIDA PLUS – 90x15mm
Meio de cultura seletivo inovador para o isolamento e diferenciação das principais espécies de Candida, incluindo a Candida auris. Este meio de cultura é essencial para a identificação rápida e precisa, auxiliando na implementação de medidas de controle e tratamento eficazes em ambientes hospitalares.
- PLACA ÁGAR SABOURAUD DEXTROSE 2% – 90x15mm
Meio de cultura destinado ao isolamento de dermatófitos e outros fungos patogênicos, proporcionando um ambiente ideal para o crescimento e identificação de infecções fúngicas comuns.
A Plastlabor está comprometida em fornecer produtos de alta qualidade que auxiliem os profissionais de saúde a enfrentar os desafios impostos pelas infecções fúngicas. Para saber mais sobre esses e outros produtos, entre em contato com nossa equipe pelo WhatsApp (21) 2501-0888 ou pelo e-mail plabor@plastlabor.com.br.
Fontes:
https://www.nbcnews.com/health/health-news/first-case-rare-sexually-transmitted-fungal-infection-reported-us-rcna155275

